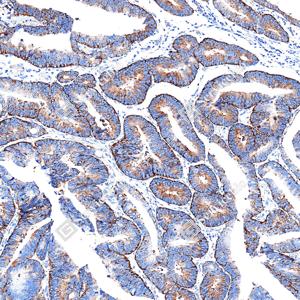
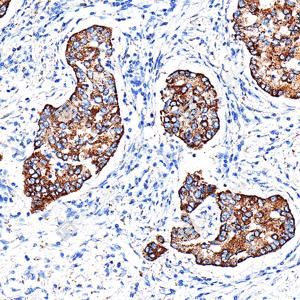
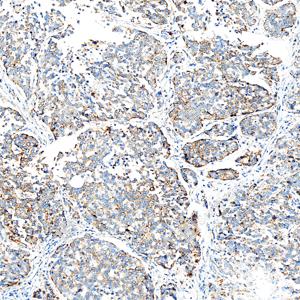

Recombinant Anti-SREBP1 antibody (Rabbit mAb)
- 50 μL
产品信息
蛋白质全称 | 固醇调节元件结合蛋白1 |
别名 | bHLHd1, SREBF1, SREBP-1, SREBP 1c, SREBP1, Class D basic helix-loop-helix protein 1, Transcription factor SREBF1, SREBP1a, sterol regulatory element binding transcription factor 1 |
Uniprot ID | P36956 |
免疫原 | 人SREBP1重组蛋白 |
抗体亚型 | IgG |
纯化方式 | 亲和纯化 |
亚细胞定位 | 内质网, 高尔基体, 膜, 细胞核 |
应用
| 应用 | 物种 | 稀释 | 阳性样品 |
| IHC/IF 免疫组织化学/免疫荧光 | 人 | 1: 1000-1: 2000 | 结肠癌, 子宫癌, 肝癌 |
背景
SREBP1, also known as SREBF1, a member of the basic helix-loop-helix-leucine zipper (bHLH-Zip) transcription factor family, are transcription factors that bind to a sequence in the promoter of different genes, called sterol regulatory element-1 (SRE1). The protein is synthesized as a precursor that is attached to the nuclear membrane and endoplasmic reticulum. Following cleavage, the mature protein translocates to the nucleus and activates transcription by binding to the SRE1. Sterols inhibit the cleavage of the precursor, and the mature nuclear form is rapidly catabolized, thereby reducing transcription.
图像
| IHC检测SREBP1蛋白(货号 GB153804). 样品: 人结肠癌, 4%多聚甲醛 (货号G1101) 固定12-24小时. 抗原修复: Tris-EDTA抗原修复液(pH 9.0) (G1203), 100℃, 25分钟. —抗: 1: 2000稀释, 4℃ 孵育过夜. 二抗: S-vision免疫组化多聚二抗(山羊抗兔),即用型 (货号G1302), 室温孵育20分钟. |
| IHC检测SREBP1蛋白(货号 GB153804). 样品: 人结肠癌, 4%多聚甲醛 (货号G1101) 固定12-24小时. 抗原修复: Tris-EDTA抗原修复液(pH 9.0) (G1203), 100℃, 25分钟. —抗: 1: 2000稀释, 4℃ 孵育过夜. 二抗: S-vision免疫组化多聚二抗(山羊抗兔),即用型 (货号G1302), 室温孵育20分钟. |
| IHC检测SREBP1蛋白(货号 GB153804). 样品: 人子宫内膜癌, 4%多聚甲醛 (货号G1101) 固定12-24小时. 抗原修复: Tris-EDTA抗原修复液(pH 9.0) (G1203), 100℃, 25分钟. —抗: 1: 2000稀释, 4℃ 孵育过夜. 二抗: S-vision免疫组化多聚二抗(山羊抗兔),即用型 (货号G1302), 室温孵育20分钟. |
| IHC检测SREBP1蛋白(货号 GB153804). 样品: 人肝癌, 4%多聚甲醛 (货号G1101) 固定12-24小时. 抗原修复: Tris-EDTA抗原修复液(pH 9.0) (G1203), 100℃, 25分钟. —抗: 1: 2000稀释, 4℃ 孵育过夜. 二抗: S-vision免疫组化多聚二抗(山羊抗兔),即用型 (货号G1302), 室温孵育20分钟. |
| IHC检测SREBP1蛋白(货号 GB153804). 样品: 人肺癌, 4%多聚甲醛 (货号G1101) 固定12-24小时. 抗原修复: Tris-EDTA抗原修复液(pH 9.0) (G1203), 100℃, 25分钟. —抗: 1: 2000稀释, 4℃ 孵育过夜. 二抗: S-vision免疫组化多聚二抗(山羊抗兔),即用型 (货号G1302), 室温孵育20分钟. |
| IHC检测SREBP1蛋白(货号 GB153804). 样品: 人肺癌, 4%多聚甲醛 (货号G1101) 固定12-24小时. 抗原修复: Tris-EDTA抗原修复液(pH 9.0) (G1203), 100℃, 25分钟. —抗: 1: 2000稀释, 4℃ 孵育过夜. 二抗: S-vision免疫组化多聚二抗(山羊抗兔),即用型 (货号G1302), 室温孵育20分钟. |
| IHC检测SREBP1蛋白(货号 GB153804). 样品: 人卵巢癌, 4%多聚甲醛 (货号G1101) 固定12-24小时. 抗原修复: Tris-EDTA抗原修复液(pH 9.0) (G1203), 100℃, 25分钟. —抗: 1: 2000稀释, 4℃ 孵育过夜. 二抗: S-vision免疫组化多聚二抗(山羊抗兔),即用型 (货号G1302), 室温孵育20分钟. |
| IHC检测SREBP1蛋白(货号 GB153804). 样品: 人扁桃体, 4%多聚甲醛 (货号G1101) 固定12-24小时. 抗原修复: Tris-EDTA抗原修复液(pH 9.0) (G1203), 100℃, 25分钟. —抗: 1: 2000稀释, 4℃ 孵育过夜. 二抗: S-vision免疫组化多聚二抗(山羊抗兔),即用型 (货号G1302), 室温孵育20分钟. |
| IF检测SREBP1蛋白(货号 GB153804)(绿色). 样品: 人结肠癌, 4%多聚甲醛 (货号G1101) 固定12-24小时. 抗原修复: Tris-EDTA抗原修复液(pH 9.0) (G1203), 100℃, 25分钟. 封闭: 3% BSA(货号GC305010)的PBS溶液, 室温孵育30分钟. —抗: 1: 2000稀释, 4℃ 孵育过夜. 二抗: Alexa Fluor 488标记山羊抗兔IgG (H+L) (货号GB25303), 1: 400稀释, 室温孵育1小时. |
| IF检测SREBP1蛋白(货号 GB153804)(绿色). 样品: 人肝癌, 4%多聚甲醛 (货号G1101) 固定12-24小时. 抗原修复: Tris-EDTA抗原修复液(pH 9.0) (G1203), 100℃, 25分钟. 封闭: 3% BSA(货号GC305010)的PBS溶液, 室温孵育30分钟. —抗: 1: 2000稀释, 4℃ 孵育过夜. 二抗: Alexa Fluor 488标记山羊抗兔IgG (H+L) (货号GB25303), 1: 400稀释, 室温孵育1小时. |
| IF检测SREBP1蛋白(货号 GB153804)(绿色). 样品: 人肺癌, 4%多聚甲醛 (货号G1101) 固定12-24小时. 抗原修复: Tris-EDTA抗原修复液(pH 9.0) (G1203), 100℃, 25分钟. 封闭: 3% BSA(货号GC305010)的PBS溶液, 室温孵育30分钟. —抗: 1: 2000稀释, 4℃ 孵育过夜. 二抗: Alexa Fluor 488标记山羊抗兔IgG (H+L) (货号GB25303), 1: 400稀释, 室温孵育1小时. |
| IF检测SREBP1蛋白(货号 GB153804)(绿色). 样品: 人卵巢癌, 4%多聚甲醛 (货号G1101) 固定12-24小时. 抗原修复: Tris-EDTA抗原修复液(pH 9.0) (G1203), 100℃, 25分钟. 封闭: 3% BSA(货号GC305010)的PBS溶液, 室温孵育30分钟. —抗: 1: 2000稀释, 4℃ 孵育过夜. 二抗: Alexa Fluor 488标记山羊抗兔IgG (H+L) (货号GB25303), 1: 400稀释, 室温孵育1小时. |
储存
| 储存条件 | 在-20℃下储存一年, 避免反复冻融. |
| 储存缓冲液 | 含0.15% ProClin300防腐剂, 100 μg/mL牛血清白蛋白和50%甘油的磷酸盐缓冲液. |
NOTE:
1.This product is intended for research only.
2.This product is recommended to dilute with the Primary Antibody Dilution Buffer (G2025).
| 货号 | 名称 | 规格 | 价格 | 操作 |
|---|
| 货号 | 名称 | 规格 | 价格 | 操作 |
|---|